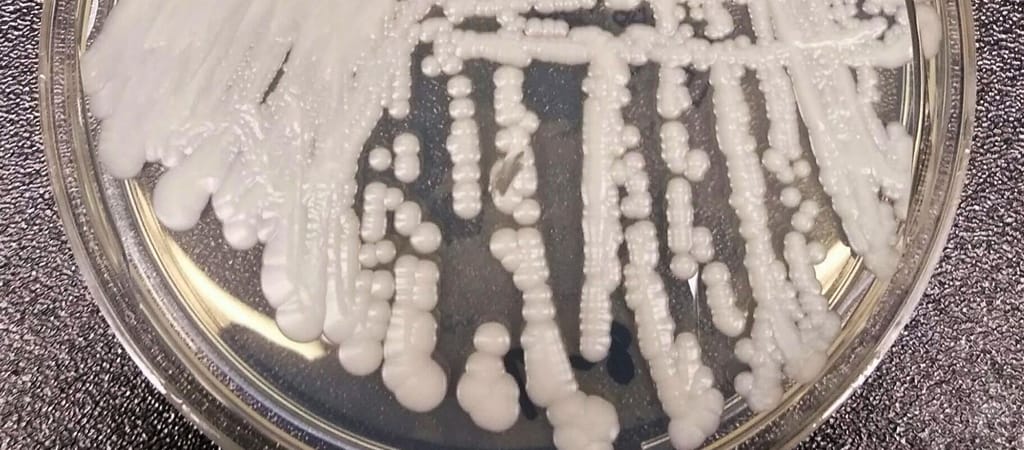

Világszerte évi 3,8 millió ember halhat meg gombás fertőzések miatt, és ebből nagyon sok halálesetet okozhat kizárólag a gomba. Ez jelentős emelkedés a 10 évvel ezelőtti adatokhoz képest.
Ugyan a The Last of Us messze van, de az elmúlt évtizedben jelentősen megugrott a gombás fertőzések és halálozások száma világszerte – mutat rá egy új, a The Lancet Infectious Diseases folyóiratban publikált tanulmány.
A kapcsolódó vizsgálatokat David Denning, a Manchesteri Egyetem gombafertőzésekre szakosodott kutatója, valamint csapata jegyezte – ők 2012-ben már végeztek egy hasonló elemzést, és akkor arra jutottak, hogy évi körülbelül kétmillió ember hal bele ilyen fertőzésekbe. Most azonban kiderült, hogy egy évtized leforgása alatt ez a szám csaknem megduplázódott.
Denning és csapata a friss tanulmányban arra volt kíváncsi, hogy 2019 és 2021 között mennyire voltak gyakoriak – és halálosak – az ilyen fertőzések. Ennek érdekében több tucat publikációt elemeztek ki, melyek összesen több mint 120 különböző ország adataira támaszkodtak.
A pontos eredmények azt mutatják, hogy – globálisan – évi 6,5 millió gombás fertőzés történik, a halálesetek száma pedig 3,8 millióra tehető. Ez utóbbiból a kalkulációk alapján körülbelül 2,5 millió írható közvetlenül a gomba számlájára.
Nem pont úgy, mint a The Last of Usban, de a gombák veszélyesebbé válhatnak
A horrorsorozat első évada után a biológusok elmondják: már csak a felmelegedés miatt is több gombafertőzés fenyeget.
Érdekes adalék, hogy a fertőző betegségek együttesen körübelül 14 millió halálesethez járulnak hozzá, vagy okoznak közvetlenül minden évben világszerte.
De visszakanyarodva a gombákra, ezek jellemzően ritkábban fertőzik meg az embert, mint a baktériumok vagy a vírusok – ennek oka, hogy a legtöbb gombafaj nem tud sokáig életben maradni a meleg emberi szervezetben, és az immunrendszer is viszonylag ellenálló velük szemben.
Az elmúlt évtizedekben ugyanakkor több tényező is változtatott ezen, az egyik ilyen például az éghajlatváltozás. Ennek hatására hőtűrőbbé válhattak egyes fajok, mint például a Candida auris.
Kifejlesztették a védőoltást, ami hatékony lehet a halálos gombás fertőzések ellen
Hamarosan embereken is kipróbálhatják az Egyesült Államokban azt a vakcinát, ami a három leggyakoribb invazív gombás fertőzés ellen nyújthat védelmet.
Sok esetben – jegyzi meg a Gizmodo – más egészségügyi problémákkal is összefüggésbe hozhatók a gombás fertőzések, de Denning számításait az is árnyalhatja, hogy nem vette figyelembe a koronavírus-világjárvány lehetséges hatásait. Azt ugyanakkor kiemelte a szakember, hogy a halálesetek közül sokat meg lehetett volna előzni, ha az orvosok időben felismerik a gombás betegségeket.
Ha máskor is tudni szeretne hasonló dolgokról, kövesse a HVG Tech rovatának tudományos felfedezésekről is hírt adó Facebook-oldalát.
 Ajándékozz éves hvg360 előfizetést!
Ajándékozz éves hvg360 előfizetést!